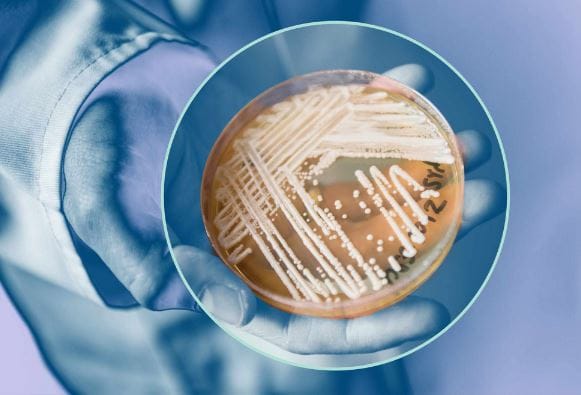
Discours alarmiste de la bureaucratie sanitaire sur une prochaine « pandémie »

Face à la fin des vaccins COVID pour les femmes enceintes, la bureaucratie sanitaire US riposte
L’administration Trump a supprimé la recommandation officielle de vaccination COVID-19 pour les femmes enceintes, déclenchant une vive opposition de 30 organisations médicales américaines. Dans une lettre ouverte, l’American College of Obstetricians and Gynecologists (ACOG) exige le maintien de la couverture vaccinale, alertant sur les risques mortels pour cette population vulnérable. Pour autant, les Centres pour le contrôle et la prévention des maladies (CDC) américains n’ont jamais pris le so
Lalaina Andriamparany